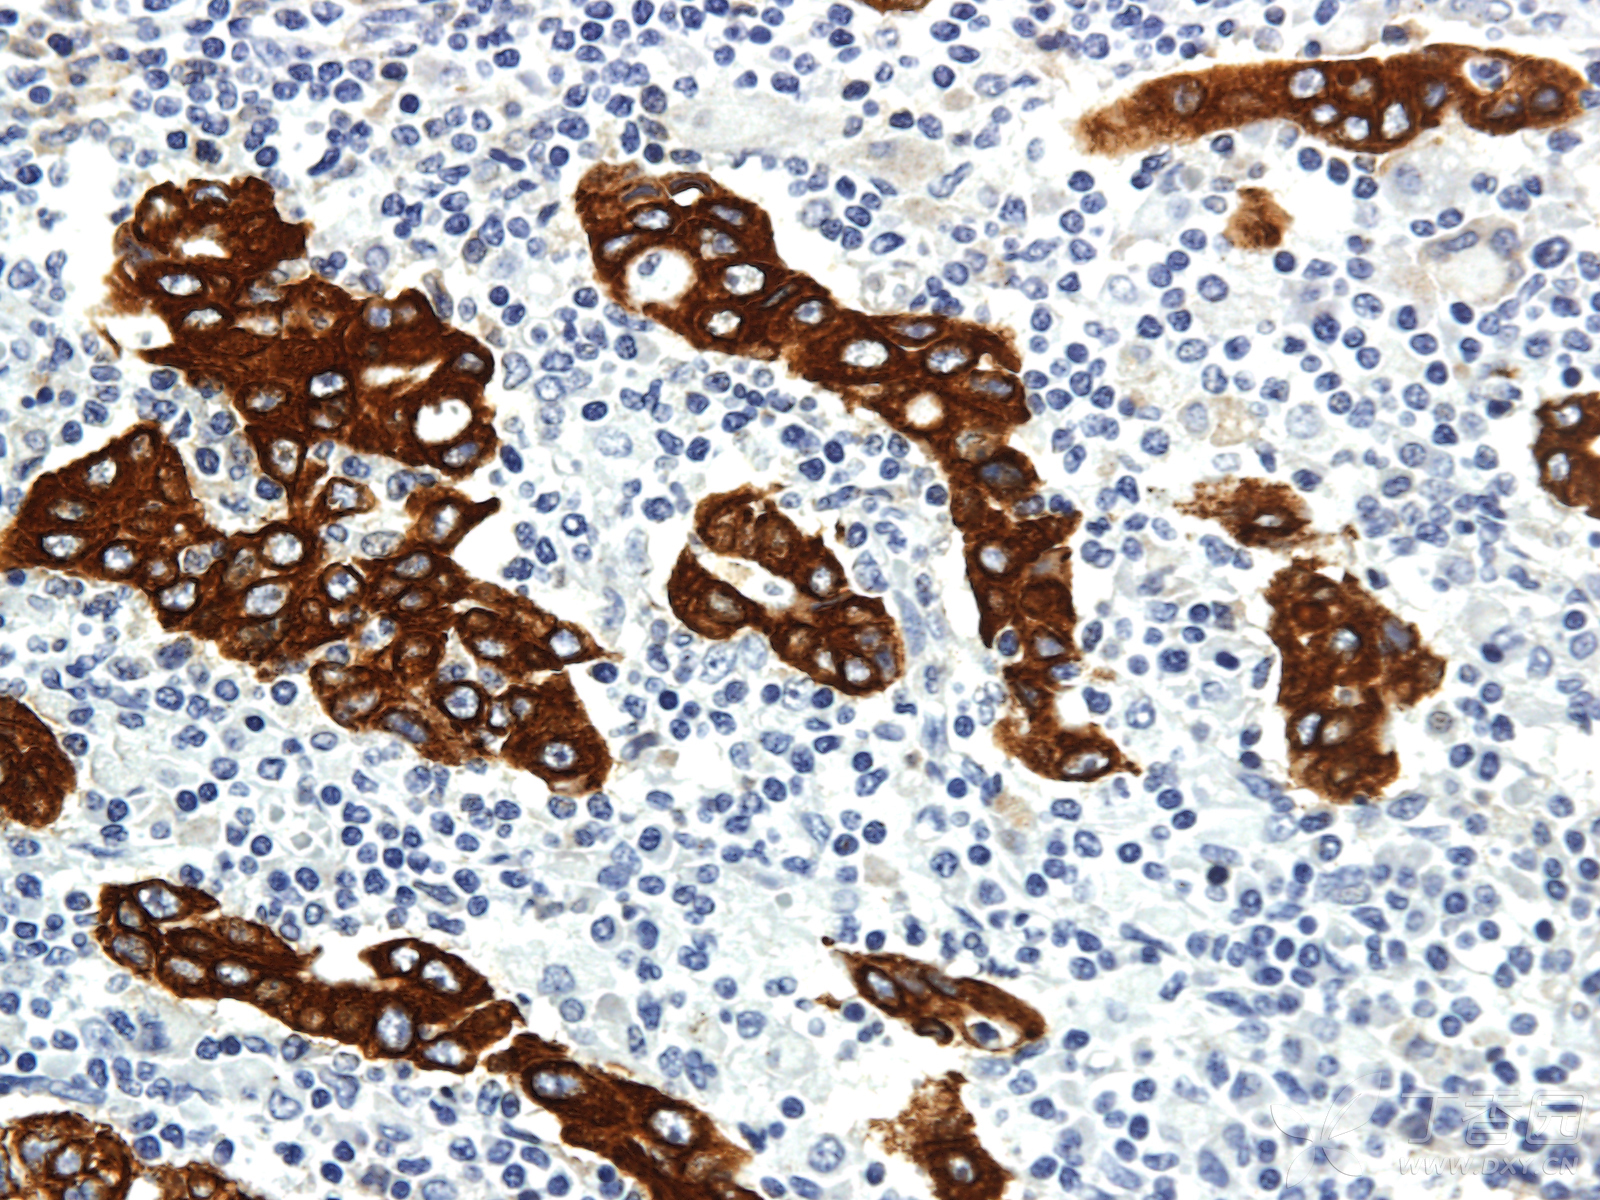
【原创】病理学之免疫组化染色篇

免疫组化

20200907免疫组化组图
图片尺寸827x1061
免疫组化
图片尺寸1356x1108
上海威奥直肠癌免疫组化文献11
图片尺寸1654x2173
你也可以学会的简单生信分析 免疫组化发2分 sci
图片尺寸640x726
求助帖免疫组化染色出现阳性结果位置不对
图片尺寸4096x3277
【原创】病理学之免疫组化染色篇
图片尺寸2592x1728
pdl1免疫组化的那些事二
图片尺寸660x495
免疫组化(ihc)
图片尺寸650x501
免疫组化,核周围的蓝色?
图片尺寸4538x7657
【原创】病理学之免疫组化染色篇
图片尺寸1600x1200
读文献,学病理-乳腺癌部分免疫组化详解(一)
图片尺寸1400x1050
免疫组化
图片尺寸1670x1368
一次染色流程检测多种抗原全自动多色免疫组化完整解决方案
图片尺寸5440x3648
肺鳞癌的免疫组化报告求大神指教
图片尺寸900x1200
免疫组化或对消化道肿瘤有预测及预后意义?
图片尺寸1025x1712
【原创】病理学之免疫组化染色篇
图片尺寸1920x1440
干货免疫组化的成功经验和失败教训看这篇就够了
图片尺寸900x600
免疫组化结果求解!
图片尺寸1024x767
腹水蜡块细胞学免疫组化
图片尺寸1916x1050
读文献,学病理-乳腺癌部分免疫组化详解(三)
图片尺寸1400x1057